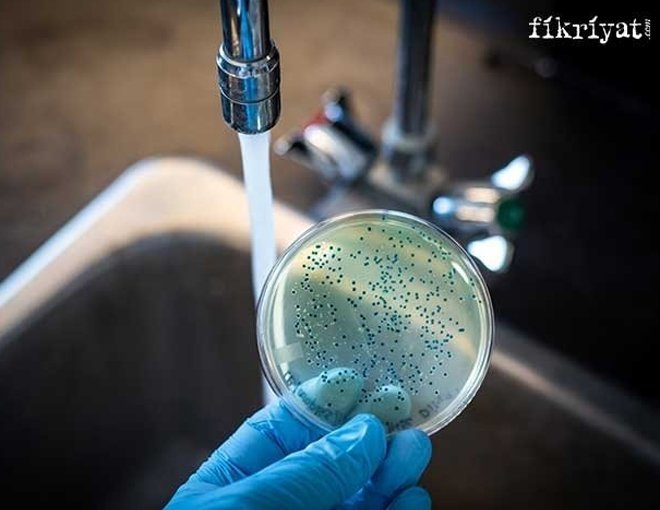

Koronafobi insan psikolojisini nasıl etkiler? Röportaj 📸
Koronavirüsün neden olduğu kaygı, milyonlarca insanın ruh sağlığını da etkiledi. Hala etkisini sürdüren salgın ile mücadele edilirken yaşanan endişe ve belirsizlik duygusal sorunlara neden oluyor. Yazarımız Prof. Dr. Sefa Saygılı "Koronavirüsün insan psikolojisi üzerindeki etkileri nelerdir? Pandemi hangi psikolojik hastalıkları tetikleyebilir? Covid-19 kaygısını tetikleyen unsurlar neler? Salgında psikolojimizi korumak için neler yapmalıyız?" gibi önemli soruları Fikriyat.com için cevaplandırdı.
➡ Salgınlar, geçmişte de büyük kayıplara neden oldu. Bundan dolayı insanların korkulu rüyası haline geldi. Bu büyük salgınlardan biri de hala etkisi altına olduğumuz koronavirüs.
➡ Koronavirüsün neden olduğu kaygı milyonlarca insanın ruh sağlığını da etkiledi. Hala etkisini sürdüren virüs ile mücadele edilirken yaşanan endişe, korku, izolasyon ve belirsizlik, duygusal sorunlara neden oluyor.
📌 Hal böyleyken yazarımız Prof. Dr. Sefa Saygılı ile koronavirüsün psikolojik etkilerini ve bunlarla nasıl başa çıkacağımızı konuştuk.
➡ Tüm dünyayı saran koronavirüsün birçok ruhsal tepkiye neden olduğunu belirten Prof. Dr. Sefa Saygılı bunun nedenlerini şöyle açıkladı:
"Koronavirüs, birçok ruhsal tepkilere neden oluyor. En başta medya ve insanlar, devamlı bununla meşgul. Toplumsal ve ekonomik hayatımızı her yönden etkiliyor. Çevremizde hastalığa yakalananlar, karantinaya alınanlar, hastaneye yatırılanlar, solunum cihazlarına takılanlar var. Bu arada lokantalar büfeler kapalı, pek çok iş yeri kapalı. İnsanlar online işlerini görmeye çalışıyor, toplantılar o şekilde oluyor. Okullar kapalı her şeyden önemlisi. Yani bütün hayatımızı felç etmiş durumda. Hepsine bağlı olarak da psikolojimiz etkileniyor."
➡ Koronavirüsün fobi denilen abartılı korkulara ve yoğun endişelere yol açtığını belirten Prof. Dr. Sefa Saygılı, pandeminin ortaya çıkarabileceği hastalıklar hakkında şunları söyledi:
"En başta anksiyete dediğimiz bir kaygı durumu ortaya çıkabiliyor. Koronafobi dediğimiz korona korkusu ortaya çıkabiliyor. Ölüm fobisini arttırıyor. Bulaşma ve bulaştırma korkusunu arttırıyor. Böyle pek çok psikolojik rahatsızlıklara yol açıyor."
➡ Bazı kişilerin virüse yakalanmadığı halde hasta olduğunu düşünerek, hastaneleri dolaştığını ve adeta kendine eziyet ettiğini belirten Saygılı, bu kimselerin 'psiko-korona' olarak adlandırıldığını belirtti. Virüsü bulaştırma kaygısıyla insanlardan uzak duran bu kişilerdeki belirtileri şöyle sıraladı:
"Psiko-koronada öncelikle kişi, en ufak öksürdüğünde veya başı ağrıdığında kendisine virüs bulaştığını zannediyor. Bu kimselerin bedenini ateş basar ama baktığınızda bir ateş yükselmesi yoktur."
➡ Medyadaki bazı abartılı haberlerin de etkisiyle her an koronavirüse yakalanacağını düşünerek bunu bir takıntı haline getiren kimselerde koronafobi oluşuyor. Prof. Dr. Sefa Saygılı, böyle vakalar ile sıklıkla karşılaşıldığını belirterek bu kimselerin hayatı kendine zehir edecek dereceye vardırdığını söyleyerek konuşmasını şöyle sürdürdü:
"Diyelim ki marketteki poşetten veya yolda giderken bile koronavirüs bulaşabilir diye bir habere takılıyor. Bundan dolayı hareket edemez hale geliyor. Devamlı koronayı düşünüyor, bununla ilgili haberleri takip ediyor ve tedbirleri abartıyor. Birkaç kat maske takıyor. Nefes alamayacak duruma geliyor. Elini abartılı şekilde, defalarca yıkıyor. Hastalık bulaşır diye hiçbir yere çıplak elle dokunamıyor. Abartıya kaçmak doğru değil. Çünkü o da bir psikolojik rahatsızlık."